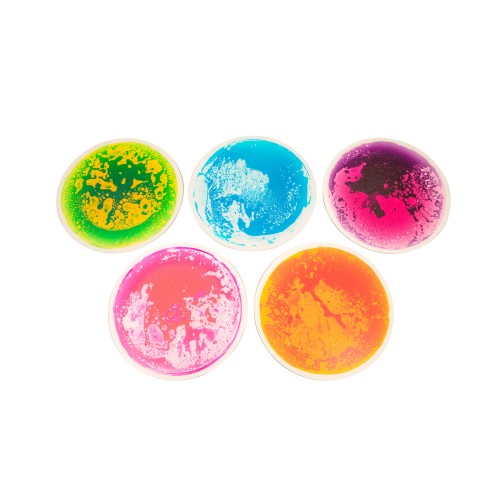
Liquid Sensory Floor Circles, Diameter 50 cm. Set 5 Units

- home
- General
- Psychomotricity & Special Education
- Sensorial Activity
- Liquid Sensory Floor Puzzle Hexagon, 6 Pieces of 33 x 33cm.
Liquid Sensory Floor Puzzle Hexagon, 6 Pieces of 33 x 33cm.
Liquid Sensory Floor Puzzle Hexagon, 6 Pieces of 33 x 33cm.
43831900
In stock
Warning: Last items in stock!
Customers who bought this product also bought:
Stick 1,20 Mt.
Sports spike to improve your training and...
Hydro Ball System...
Water-fillable medicine ball designed for...
Sensorial ball with...
Sensorial ball with spiky surface
Balance path islands...
Balancing and learning game that offers...
Tecnocaucho LITE...
The Tecnocaucho LITE Fitness Ball is a...
Balance rotary plate
Plates for balance, stability, lineup and...
Arquitecture Tubes
3D Construction creative toy, easy to assembly....
Information
Categories
- General
- Gyms
- Skate
- Rhythmic Gymnastics
- NOVEDADES
- Offers
Store Information
- Amaya Sport S.L. , Polígono Industrial Talluntxe, Calle A, Naves 16 a 20, 31110 - Noain (Navarra, Spain)
- Call us now: (+34) 948 317 162
- Email: info@amayasport.com
Copyright © 2026 Amaya Sport, SL


AMAYA SPORT ha sido beneficiaria de la convocatoria de 2024 de las “Ayudas a pymes para la contratación de personas para la ejecución del plan de internacionalización de la empresa”, enmarcada en el Plan Internacional de Navarra

Esta empresa ha recibido una ayuda cofinanciada por el gobierno de Navarra y el Fondo Europeo de Desarrollo regional (40%) a través del Programa Operativo FEDER 2021-2027 de Navarra
Esta empresa ha recibido una subvención del Gobierno de Navarra al amparo de la convocatoria de ayudas a proyectos Investigación y Desarrollo I+D 2024.